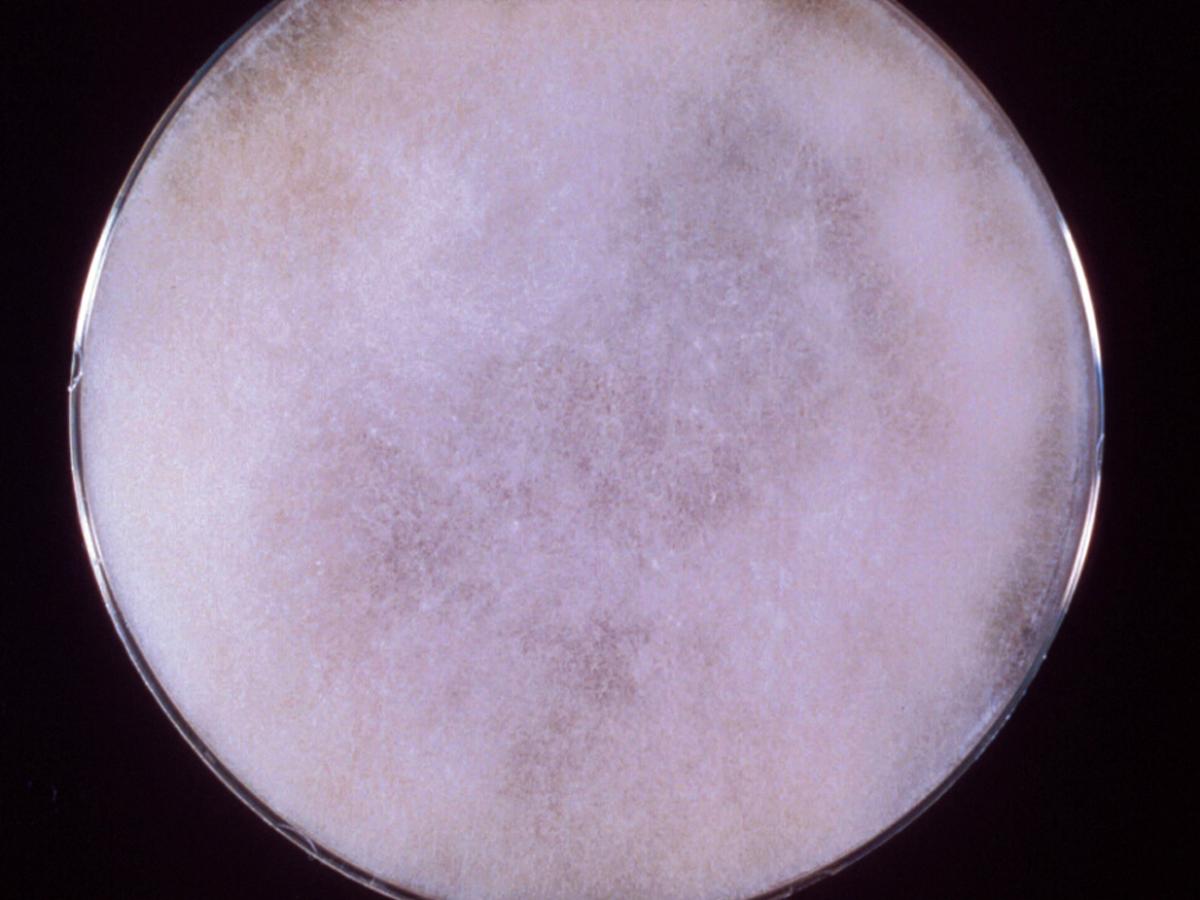
Culture

Status message
Correct! Excellent, you have really done well. Please find additional information below.
Unknown 15 = Saksenaea vasiformis
Direct microscopy (H&E stained tissue section): Tissue morphology in zygomycosis showing distinctive infrequently septate thin walled hyphae with focal bulbous dilations and irregular branching, typical for those species belonging to the Mucorales.

Culture: Colonies are fast growing, downy, white with no reverse pigment
Microscopy: Hyphae are broad, non-septate hyphae typical of a zygomycetous fungus.

Sporangia are typically flask-shaped with a distinct spherical venter and long-neck, arising singly or in pairs from dichotomously branched, darkly pigmented rhizoids. Columella are prominent and dome-shaped. Sporangiospores are small, oblong, 1-2 x 3-4 um in size, and are discharged through the neck following the dissolution of an apical mucilaginous plug.

Agar block method to induce sporulation of Saksenaea vasiformis.
Laboratory identification of some zygomycetous fungi, especially Apophysomyces elegans and Saksenaea vasiformis may be difficult or delayed because of the mould's failure to sporulate on the primary isolation media or on subsequent subculture onto potato dextrose agar. Sporulation may be stimulated by the use of nutrient deficient media, like Czapek Dox agar, cornmeal-glucose-sucrose-yeast extract agar, or by using the agar block method described by Ellis and Ajello (1982) and Ellis and Kaminski (1985).
Briefly, a small block of agar is cut from a well established culture grown on PDA and is placed in the centre of petri dish containing 1% agar in distilled water. After 21 days at 26C look for sporangium formation at the periphery of the petri dish.

Comment: Saksenaea vasiformis is a rare human pathogen that has also been associated with invasive lesions following traumatic implantation of the fungus and rhinocerebral, cutaneous and disseminated types of infection have also been reported. S. vasiformis appears to have a world-wide distribution in association with soil.
About Saksenaea Back to virtual assessment